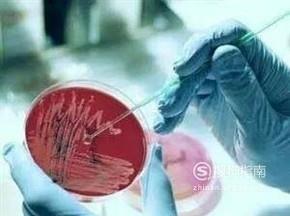

最佳回答
本文由作者推荐
简要回答
你知道如何测试你用的口红里含不含重金属吗?一起来看看吧

详细内容
- 01
将口红滴于清水中,如果不蘸着杯壁,不漂浮在杯面,不沉在杯底,那就说明口红品质还可以。如果沉底,就说明含有重金属。

- 02
可以对比正品不含重金属的口红和含重金属的口红在显色色泽和外观气味上都有明显不同。

- 03
将口红抹在重金属测试纸上,查看重金属测试纸反应。

- 04
如果重金属测试纸颜色变深或者变成其他颜色,就说明口红含有重金属。如果重金属测试纸没变色,一般说明口红不含重金属。
广告位
点击排行
热点追踪
广告位





















